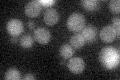
YER142C
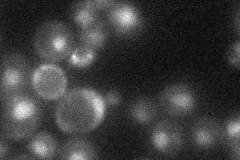
YER142C
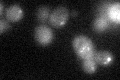
YER142C
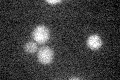
YER142C

View description
3-methyl-adenine DNA glycosylase involved in protecting DNA against alkylating agents; initiates base excision repair by removing damaged bases to create abasic sites that are subsequently repaired
Localization:
Intensity:
Fold change:
Significance:
-
C’ GFP library in SD
below threshold15.32 -
N' NOP1pr-GFP in SD

nucleus116.565 -
N' TEF2pr-mCherry in SD

nucleus187.045 -
N' NATIVEpr-GFP in SD
nucleus23.6759 -
N' TEF2pr-VC and Cyto-VN in SD

nucleus49.5101 -
C’ GFP library in SD+DTT
cytosol15.981.04No -
C’ GFP library in SD+H2O2

cytosol15.881.03No -
C’ GFP library in Starvation Media
cytosol19.691.28No -
C’ GFP library on the background of Pup2-DaMP

below threshold -
C’ GFP library on the background of CCT mutant

below threshold16.61691.08409No
